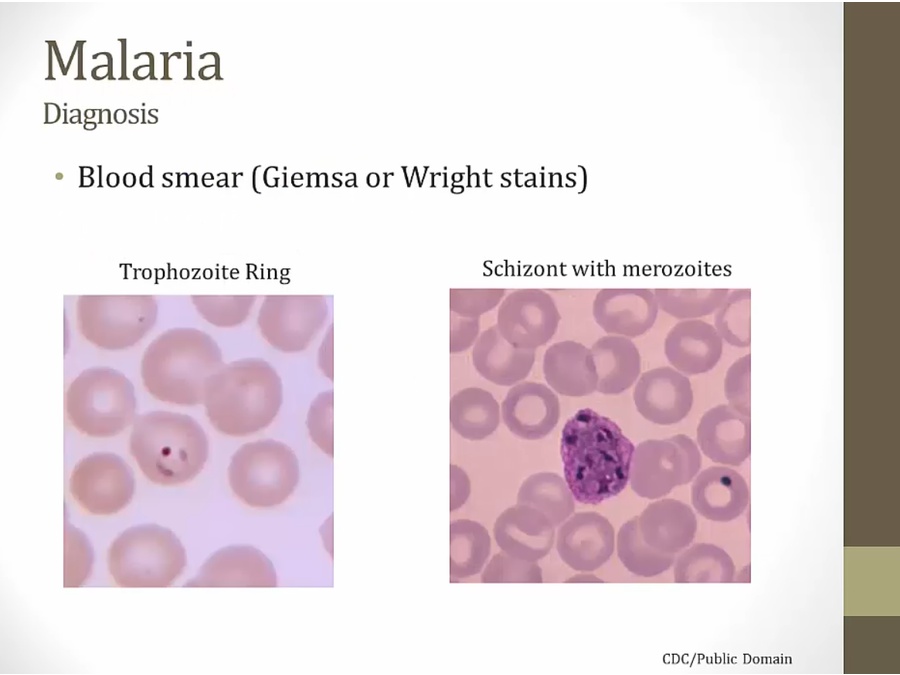

Malaria

Life cycle

sporozoite infectious form
not get sick for several weeks

schizonts: many nuclei, ready to rupture
in liver, hasn't reached RBC

daughter cells

can see on blood smears
cyclic fever whenever schizonts rupture


erythrocyte cycle cause of fever pattern
Symptoms


Vivax

primaquine the one drug that treats vivax, doesn't treat active cell
Malariae

Falciparum


Diagnosis
Protection

Duffy antigen on RBC necessary for infection
Treatment

plasmodium converts Hgb heme to nontoxic form using heme polymerase

mefloquine prophylaxis for travelers. Very vivid dreams SE


Last updated
Was this helpful?